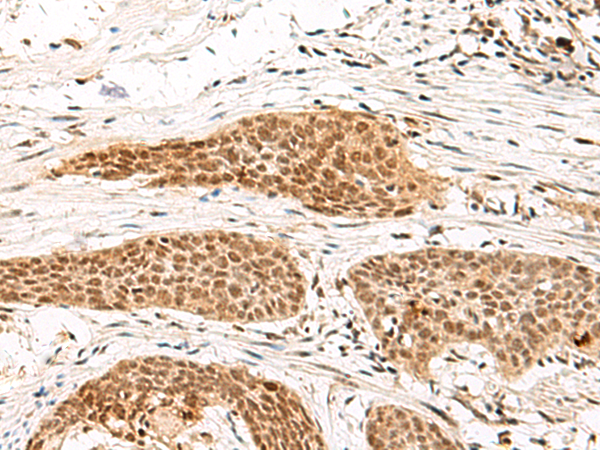

手機(jī)掃碼訪問(wèn)本站
微信咨詢
品牌:
貨號(hào):JN3075
規(guī)格: 100ul 200ul 25ul
聯(lián)系方式:17301775915
英文名稱: Anti-MDFI rabbit polyclonal antibody
別 名: MyoD family inhibitor; I-MF; I-mfa
相關(guān)類別: 一抗
儲(chǔ) 存: 冷凍(-20℃)
宿 主: Rabbit
抗 原: MDFI
反應(yīng)種屬: Human, Rat
標(biāo) 記 物: Unconjugate
克隆類型: rabbit polyclonal
技術(shù)規(guī)格
|
Background: |
This protein is a transcription factor that negatively regulates other myogenic family proteins. Studies of the mouse homolog, I-mf, show that it interferes with myogenic factor function by masking nuclear localization signals and preventing DNA binding. Knockout mouse studies show defects in the formation of vertebrae and ribs that also involve cartilage formation in these structures. |
|
Applications: |
ELISA, IHC |
|
Name of antibody: |
MDFI |
|
Immunogen: |
Fusion protein of human MDFI |
|
Full name: |
MyoD family inhibitor |
|
Synonyms: |
I-MF; I-mfa |
|
SwissProt: |
Q99750 |
|
ELISA Recommended dilution: |
5000-10000 |
|
IHC positive control: |
Human cervical cancer and Human colorectal cancer |
|
IHC Recommend dilution: |
50-300 |